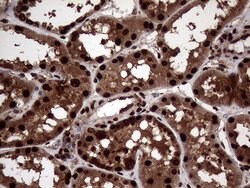
TALDO1 Mouse anti-Human, Clone: OTI2E4, liquid, TrueMAB 100 &mu;L | Buy Online | Origene Technologies | Fisher Scientific

missing translation for 'onlineSavingsMsg'
Learn More
Learn More
TALDO1 Mouse anti-Human, Clone: OTI2E4, liquid, TrueMAB™

Description
Transaldolase 1 is a key enzyme of the nonoxidative pentose phosphate pathway providing ribose-5-phosphate for nucleic acid synthesis and NADPH for lipid biosynthesis. This pathway can also maintain glutathione at a reduced state and thus protect sulfhydryl groups and cellular integrity from oxygen radicals. The functional gene of transaldolase 1 is located on chromosome 11 and a pseudogene is identified on chromosome 1 but there are conflicting map locations. The second and third exon of this gene were developed by insertion of a retrotransposable element. This gene is thought to be involved in multiple sclerosis.
Specifications
Specifications
| Antigen | TALDO1 |
| Applications | Immunohistochemistry (Paraffin), Western Blot |
| Classification | Monoclonal |
| Clone | OTI2E4 |
| Conjugate | Unconjugated |
| Formulation | PBS with 1% BSA, 50% glycerol and 0.02% sodium azide |
| Gene | TALDO1 |
| Gene Accession No. | P37837 |
| Gene Alias | TAL, TAL-H, TALDOR, TALH |
| Gene Symbols | TALDO1 |
| Show More |
Product Title
By clicking Submit, you acknowledge that you may be contacted by Fisher Scientific in regards to the feedback you have provided in this form. We will not share your information for any other purposes. All contact information provided shall also be maintained in accordance with our Privacy Policy.
Spot an opportunity for improvement?